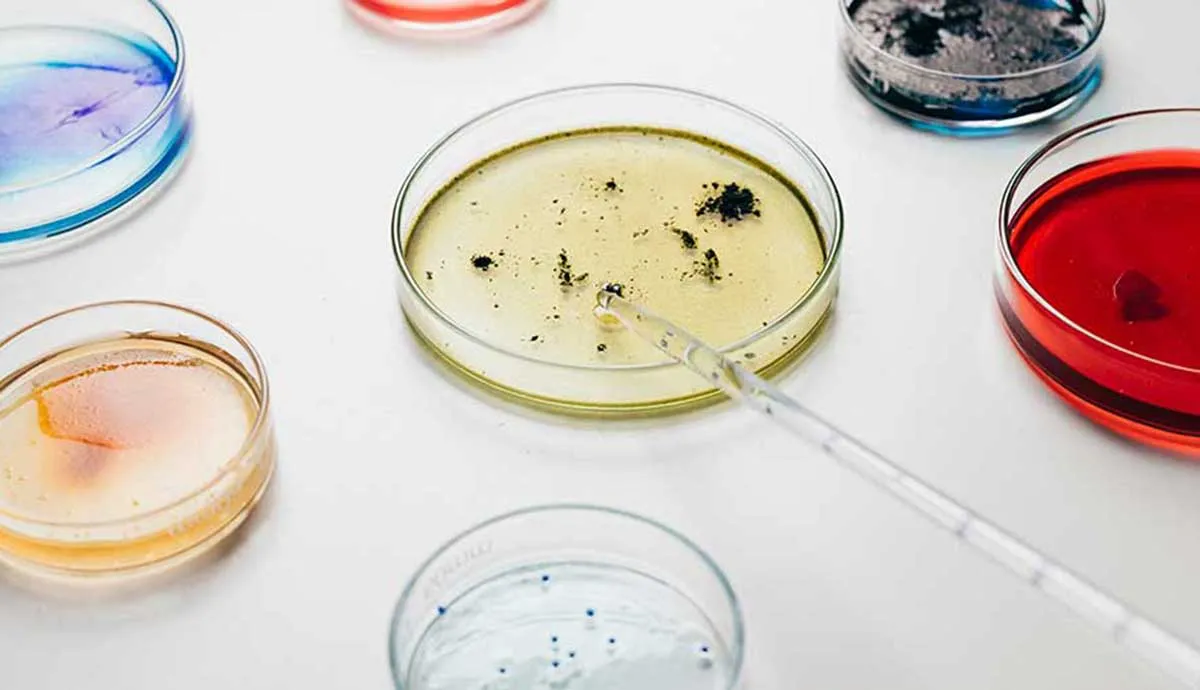
Microbe Growth

Microbe growth on plastic can deteriorate performance and also lead to undesirable staining and odor issues. As such, there’s a trend to reduce microbial populations on high-touch surfaces via the use of antimicrobials to protect material aesthetics and durability or to prevent the spread of pathogenic microorganisms.
To better evaluate how to protect plastic parts from microbial attack, Avient conducted a study to screen a variety of plastic substrates for susceptibility using American Society for Testing and Materials (ASTM) G21 (fungi susceptibility), Japanese Industrial Standard (JIS) Z2801, and modified ASTM E1428-15a (bacterial susceptibility) test standards. TPEs were determined to be most susceptible to microbial attack under the appropriate environmental conditions.
Subsequent studies then assessed the use of an antimicrobial additive, zinc pyrithione (ZPT), for potential efficacy in a variety of TPE formulations for diverse applications. ZPT proved to be very effective in protecting TPEs, reducing common bacteria populations by 99.9% or more in JIS Z2801 testing, and inhibiting fungal growth (rating = 0) according to the ASTM G21 standard.
The resulting white paper unpacks the technical details and conclusions of the study, including the efficacy of GLS™ TPEs with antimicrobial additives to protect the finished, molded part.